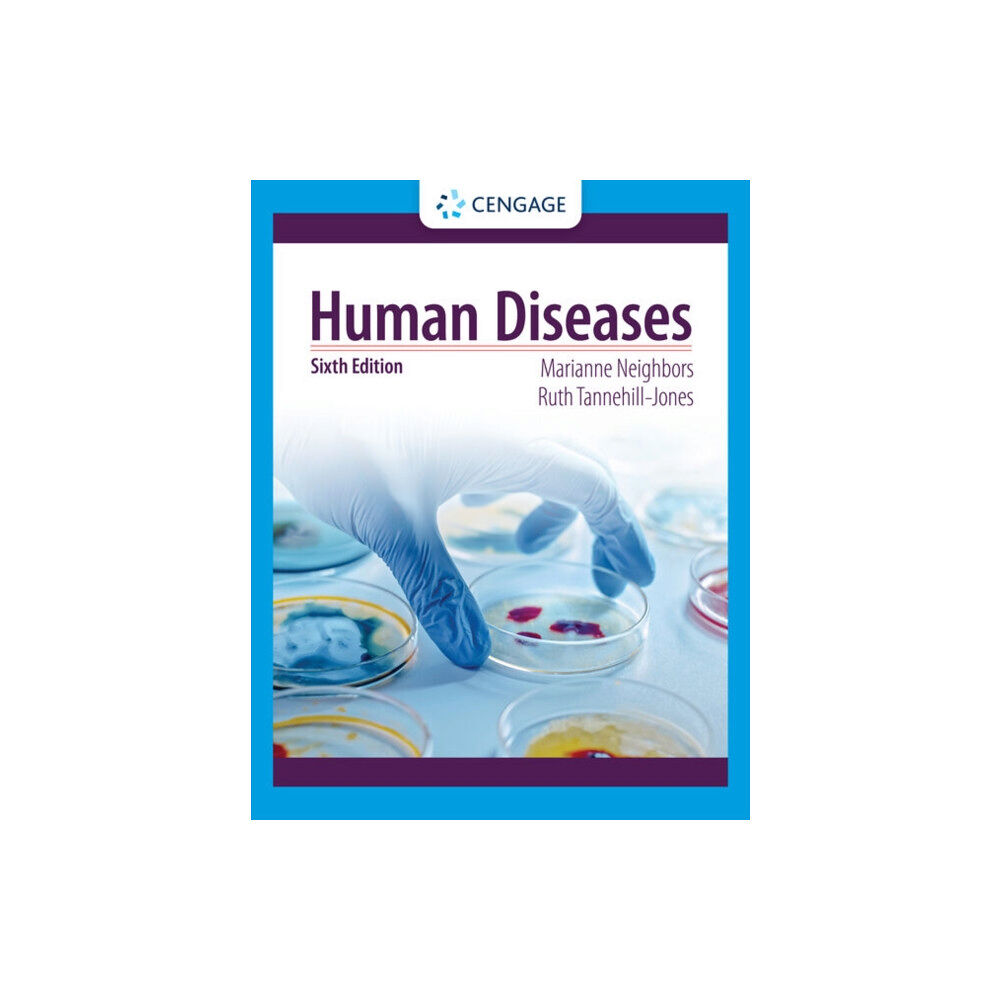
Cengage Learning, Inc Human Diseases (häftad, eng)

Designed specifically for future allied health professionals, HUMAN DISEASES, Sixth Edition, includes everything you need to know about the diseases and disorders health care providers see and treat most often. Making pathology fully accessible, this best-selling text is packed with the most current research available and reflects the latest practices from the field.
Following a basic review of anatomy and physiology, chapters present each disease''s description, etiology, symptoms, diagnosis, treatment and prevention, while detailed, full-color photos make it easier to gain a thorough understanding of key concepts. Completely up to date, the Sixth Edition includes information on new and emerging disorders, ICD-10 progress, pharmacology concerns, herbal and nontraditional remedies, current research and statistics and more.
In addition, real-life cases and interactive learning tools give you hands-on experience to help you put what you learn into practice.
| Format |
Häftad |
| Omfång |
624 sidor |
| Språk |
Engelska |
| Förlag |
Cengage Learning, Inc |
| Utgivningsdatum |
2022-10-24 |
| ISBN |
9780357618042 |